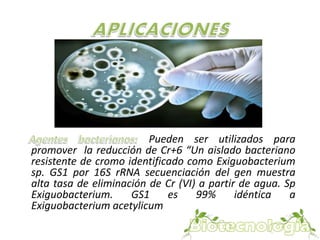
Pueden ser utilizados para 
promover la reducción de Cr+6 “Un aislado bacteriano 
resistente de cromo identificado como Exiguobacterium 
sp. GS1 por 16S rRNA secuenciación del gen muestra 
alta tasa de eliminación de Cr (VI) a partir de agua. Sp 
Exiguobacterium. GS1 es 99% idéntica a 
Exiguobacterium acetylicum

En Colombia se requiere mayor inversión del estado y el sector privado en investigación y aplicación de biotecnología ambiental, especialmente para el tratamiento de aguas residuales domésticas, industriales y del sector agropecuario. La biotecnología ofrece alternativas para minimizar el impacto ambiental negativo generado por procesos como el beneficio del café y el manejo de sus aguas residuales. Se necesitan seguir explorando el uso de microorganismos y procesos biotecnológicos para la biorremediación de contaminantes como el